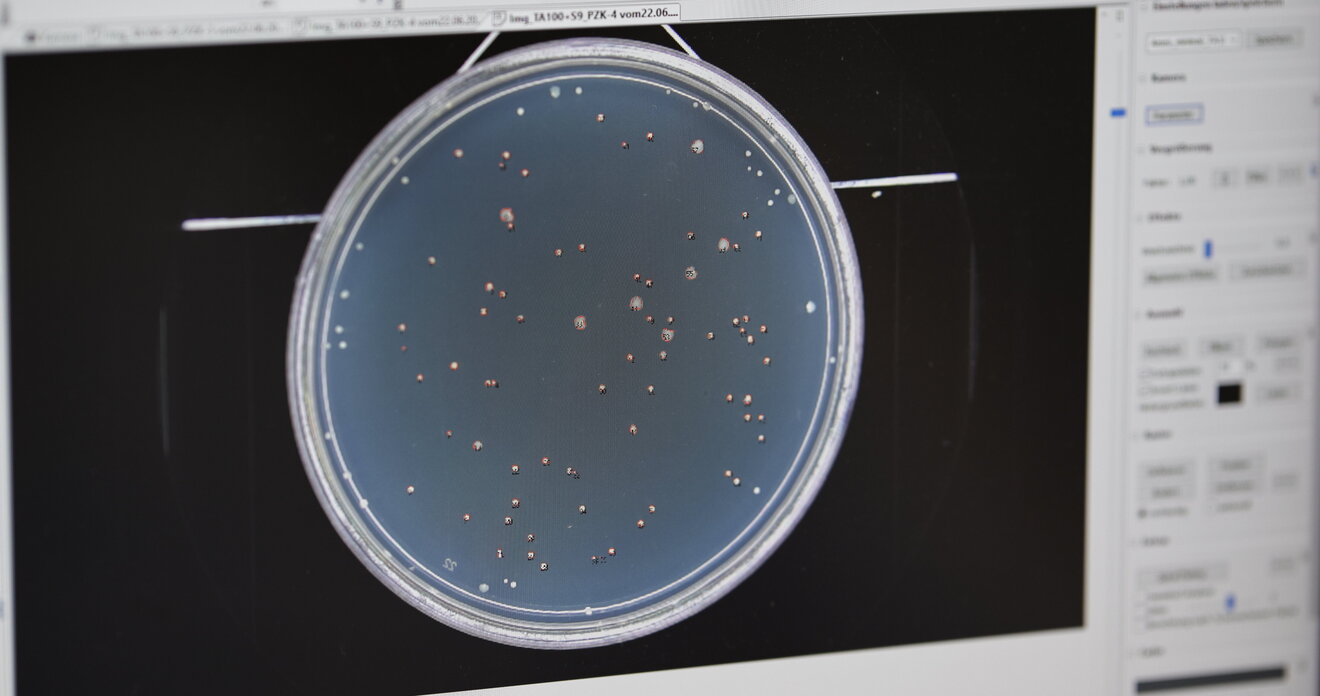

Wirkungsbezogene Analytik
Die moderne Industriegesellschaft hat in den vergangenen Jahrzehnten rund 100.000 neue Chemikalien hervorgebracht. Tag für Tag gelangen diese unter anderem über Abwässer in Oberflächengewässer und teilweise auch durch die Verwendung dieses Wassers in der Trinkwasseraufbereitung ins Trinkwasser. Besonders problematisch ist, dass nicht eine einzelne Substanz, sondern eine Mischung aller Substanzen in die Umwelt gelangen kann.
Das Grundprinzip der Gewässer- und Abwasserüberwachung besteht im Nachweis einzelner Substanzen beziehungsweise Substanzgruppen mittels chemischer Analytik. Zu diesen Substanzen gehören natürliche und synthetische Verbindungen sowie deren Umwandlungsprodukte. Veranschaulichen lässt sich dies mit einem Eisberg. Alles, was Betrachter sehen können und somit bekannt ist, lässt sich auch analysieren. Dies entspricht der Spitze des Eisbergs. Welches Wissen bleibt unterhalb der Wasseroberfläche noch verborgen?
Um nun mehr über das „Verborgene unter der Wasseroberfläche“ zu erfahren, etablierte das LANUV Anfang 2019 die wirkungsbezogene Analytik zum vorsorgenden Gewässerschutz.



Das Prinzip der wirkungsbezogenen Analytik beruht darauf, dass in einem Screening-Ansatz nicht einzelne Wirkstoffe, sondern biologische Wirkungspotenziale der Gesamtprobe in ausgewählten Zielsystemen, wie zum Beispiel Zellkulturen, nachgewiesen werden. Diese werden im alltäglichen Sprachgebrauch oft als „Effekte“ oder „Wirkungen“ bezeichnet. Die biologischen Wirkungspotenziale finden auf zellulärer Ebene statt und sind dadurch sehr selektiv. Zudem bieten sie den Vorteil, dass auch Wirkungen unbekannter Substanzen und Mischungstoxizitäten erfasst werden können.
Das LANUV führt die Untersuchungen zum Nachweis hormonähnlicher, gentoxischer und mutagener Wirkungspotenziale mit gentechnisch veränderten eukaryotischen Zellen in vitro und mit Hefe- und Bakterienzellen durch.
In der Regel handelt es sich bei den eukaryotischen Zellen um Krebszellen, die unter standardisierten Laborbedingungen permanent wachsen können. Dank schnellerer und kostengünstigerer Analysemethoden können viele Tierversuche ersetzt werden. Solche Analysen sind hervorragend geeignet, um eine erste Risikoabschätzung bezüglich der untersuchten Endpunkte vornehmen zu können.
Hormonähnliche Substanzen, sogenannte endokrine Disruptoren, stehen im Verdacht, die Gesundheit von Mensch und Tier zu beeinträchtigen, indem sie in deren natürlichen Hormonhaushalt eingreifen. Zu den essentiellen Funktionen des Hormonsystems zählen das Gleichgewicht der physiologischen Körperfunktionen wie zum Beispiel Blutdruck und Körpertemperatur, die Fortpflanzung, die Entwicklung und das Verhalten eines Individuums. Diese und viele andere Funktionen werden in den Zielgeweben über Hormone und entsprechende Hormonrezeptoren reguliert.
Um nun beurteilen zu können, welche Substanzen im Wasser für hormonähnliche Wirkungen verantwortlich sind, kann die hohe Selektivität von Hormonrezeptoren genutzt werden. Die Rezeptoren funktionieren dabei nach dem Schlüssel-Schloss-Prinzip. Liegt eine Östrogen-wirkende Substanz vor, wie beispielsweise der Wirkstoff der Antibabypille (17α-Ethinylestradiol), bindet die Substanz an den Östrogenrezeptor. Im Zellkern des Testorganismus wird dadurch ein Prozess aktiviert, durch den ein Enzym gebildet wird. Dieses Enzym kann nach Zugabe eines spezifischen Substrats mittels Lumineszenzmessung erfasst werden. Dadurch ist es möglich, auf die Menge der Östrogen-wirkenden Substanzen, die an den Rezeptor gebunden sind, zurückzurechnen.
Aber auch Umwelthormone können das Hormonsystem stören. Dazu gehören beispielsweise Flammschutzmittel, Bestandteile von Kunststoffen, Inhaltsstoffe von Kosmetika und Reinigungsmitteln und Wirkstoffe von Medikamenten im Wasser.


Zur Früherkennung reversibler oder irreversibler Schäden des Erbguts (DNA) durch chemische Substanzen können Wirkungstests eingesetzt werden. Um das sogenannte gentoxische Potenzial abschätzen zu können, müssen mindestens drei unterschiedliche Endpunkte beurteilt werden, da jedes dieser Ereignisse in die Entstehung von Krebs und von vererbbaren Krankheiten involviert sein kann:

- Der Mikrokerntest erkennt Änderungen der Chromosomenzahl und strukturelle Schäden der DNA.
- Der Ames-Test identifiziert Genmutationen. Seine Bewertungssicherheit kann durch den parallelen Einsatz des umu-Testes erhöht werden.

- Der umu-Test wird seit 1997 durch das Landesumweltamt NRW beziehungsweise als Nachfolgeorganisation durch das LANUV standardisiert im Vollzug eingesetzt und hat 2019 Einzug in die Parameterliste der akkreditierten Verfahren gefunden.
Externer Inhalt
Schutz Ihrer Daten
An dieser Stelle haben wir den Inhalt eines Drittanbieters, bspw. YouTube, X, Instagram etc., eingebunden. Bitte bestätigen Sie über den Button, dass Sie damit einverstanden sind, diese Inhalte zu sehen!
Ich bin damit einverstanden, dass mir externe Inhalte angezeigt werden. Damit können personenbezogene Daten an Drittplattformen übermittelt werden. Mehr dazu in unserer Datenschutz.

